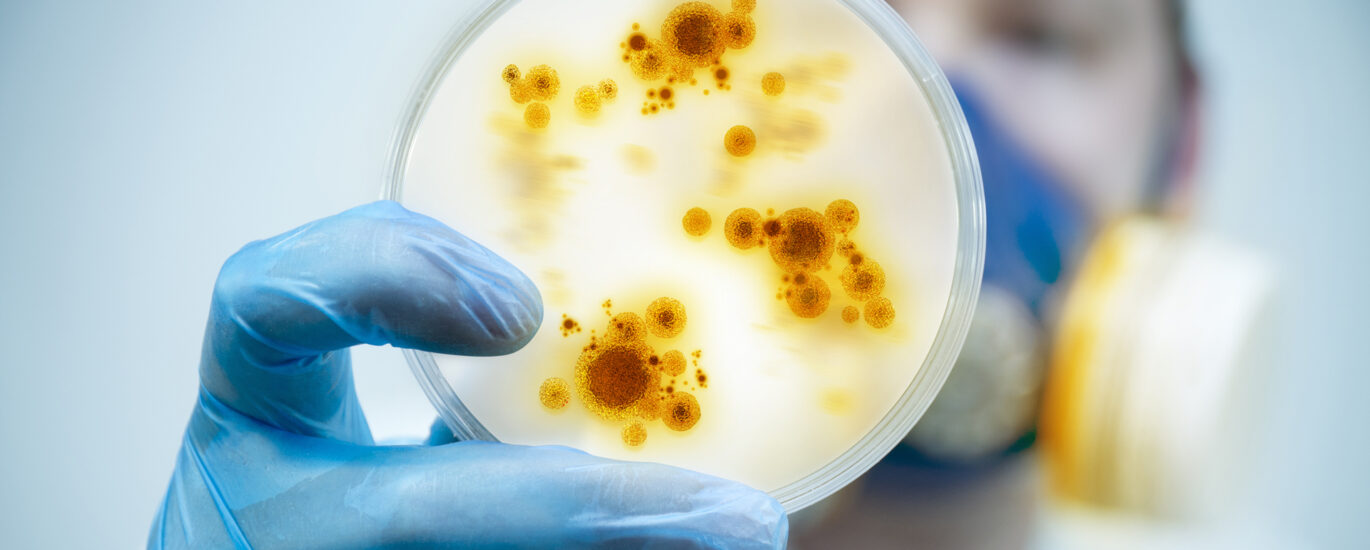
Microbial Gene Editing Services Market

Demand for microbial gene editing services market is projected to be worth US$ 5.35 billion globally in 2022 and to increase at a CAGR of 19% to US$ 30.5 billion globally from 2022 to 2032.
A technique called microbial gene editing allows for the modification of an organism’s DNA. The process of creating novel medicinal therapies is being altered by microbial gene editing. Microbial gene editing has the potential to significantly impact all aspects of life in the near future, from the treatment of diseases like sickle cell and HIV to the creation of personalised pets and designer children.
Technology called microbial gene editing allows for the modification of an organism’s DNA. The methods for creating novel medicinal treatments are changing as a result of microbial gene editing. Microbial gene editing has the potential to have a significant impact on all aspects of life in the near future, from curing diseases like sickle cell and HIV to creating personalised pets and designer children.
Get Recently Updated Report of Market as Sample Copy! https://www.futuremarketinsights.com/reports/sample/rep-gb-8521
The future will see a large increase in the occurrence of cancer, opening up opportunities for the development of new immunotherapies for diseases like cancer. For instance, the first-ever human CRISPR studies in China concentrated on treating a variety of tumours, while the first human CRISPR trials in the US are planned to target illnesses like sickle cell. The capability for the complicated requirements of system-level examination of microorganisms has been substantially increased thanks to advancements in computational tool availability and wet-lab genome editing (GE) technologies.
Targetrons, zinc finger nucleases (ZFNs), meganucleases (MNs), the CRISPR-associated nuclease Cas9, and transcription activator-like effector nucleases (TALENs) are a few examples of the microbial gene editing tools that present a significant chance for gene editing throughout the anticipated period. Through the intentional induction of targeted DNA double strand breaks, all of these methods can produce precise and accurate genetic alterations.
Microbial Gene Editing Services: Market Dynamics
In the forecast period, recent advancements in genome editing technologies show promise for the creation of novel medicines. Hundreds of diseases, both common and rare, could potentially be affected by the use of genome tools, which will greatly expand the market for microbial gene editing services during the projection period. The market for microbial gene editing services will be driven by increased focus on the development of novel antibiotics that combat bacteria resistant to antibiotics in the near future.
For instance, CRISPR technology is being used by businesses like Nemesis Bioscience and Eligo Bioscience to create antibacterial technology and remedies. The market for microbial gene editing services is driven throughout the forecast period by rising government funding as well as the development of quick, simple, and highly effective technologies. The market for microbial gene editing services may, however, be constrained in its expansion by some tool restrictions and the high cost of the editing systems.
In Case Of Any Queries, Don’t Hesitate To Contact Our Analyst! https://www.futuremarketinsights.com/ask-question/rep-gb-8521
Microbial Gene Editing Services: Region-wise Outlook
The North America market for Microbial Gene Editing Services holds the largest revenue share, due to increasing research and development and rising government funding towards the microbial gene editing research. For instance, in 2018, The US National Institutes of Health (NIH) has announced to grant US$190 million for genome editing research. Launch of genome editing program by NIH such as Somatic Cell Genome Editing programs which aims to develop tools for safe and effective genome editing in humans spur the market of North America in the forecast period.
Europe accounts for the second large revenue share in the global microbial gene editing services market, owing to increasing prevalence of disease such as HIV and Cancer and development of new innovative technology and new drug along with the increasing number skilled labors.
Asia Pacific is expected to witness rapid growth in the microbial gene editing services market, due to increasing awareness in the gene editing services in developing countries such as India and improving healthcare infrastructure. China is expected to register significant growth in the microbial gene editing services market, due to favorable regulations and advancement in the biotechnology.
For instance, the world’s first genetically edited babies was created in China in 2018. Latin America and Middle East & Africa are projected to exhibit slow growth in microbial gene editing services market, owing to lack of R&D labs, awareness and high cost of gene editing tools and systems
Microbial Gene Editing Services: Key Players
- Creative Biogene
- GeneCopoeia, Inc.
- ProteoGenix
- Thermo Fisher Scientific Inc.
- Vigene Biosciences Inc.
- Biotools Co. Ltd
- Cellecta Inc.
- InVivo Biosystems
- GenScript Biotech Corp.
- OriGene Technologies Inc.
- Synbio Technologies LLC
- Abm Inc.
- Rockland Immunochemicals Inc.
Revolutionizing Customer Engagement: Learn from Our Customization Report! https://www.futuremarketinsights.com/customization-available/rep-gb-8521
Microbial Gene Editing Services: Segmentation
The global Microbial Gene Editing Services Market is segmented on basis of tools, application and geography.
By Tools:
- Meganucleases (MNs),
- Zinc Finger Nucleases (ZFNs)
- Transcription Activator-Like Effector Nucleases (TALENs)
- CRISPR/Cas9
- Targetrons
- Peptide Nucleic Acids (PNAs)
- Triplex-Forming Oligonucleotides (TFOs)
- Structure-Guided Endonucleases(SGNs)
By Application:
- Industrial Applications
- Pharmaceutical applications
- Environmental applications
- Agricultural applications
By End User:
- Biotechnological Companies
- Pharmaceutical Companies
- Contract Research Organizations
- Academic Research Institutes
By Region:
- North America
- Latin America
- Europe
- East Asia
- South Asia and the Pacific
- Middle East and Africa
About Future Market Insights (FMI)
Future Market Insights, Inc. (ESOMAR certified, recipient of the Stevie Award, and a member of the Greater New York Chamber of Commerce) offers profound insights into the driving factors that are boosting demand in the market. FMI stands as the leading global provider of market intelligence, advisory services, consulting, and events for the Packaging, Food and Beverage, Consumer Technology, Healthcare, Industrial, and Chemicals markets. With a vast team of over 5000 analysts worldwide, FMI provides global, regional, and local expertise on diverse domains and industry trends across more than 110 countries.
Contact Us:
Future Market Insights Inc.
Christiana Corporate, 200 Continental Drive,
Suite 401, Newark, Delaware – 19713, USA
T: +1-845-579-5705
For Sales Enquiries: sales@futuremarketinsights.com
Website: https://www.futuremarketinsights.com
LinkedIn| Twitter| Blogs | YouTube